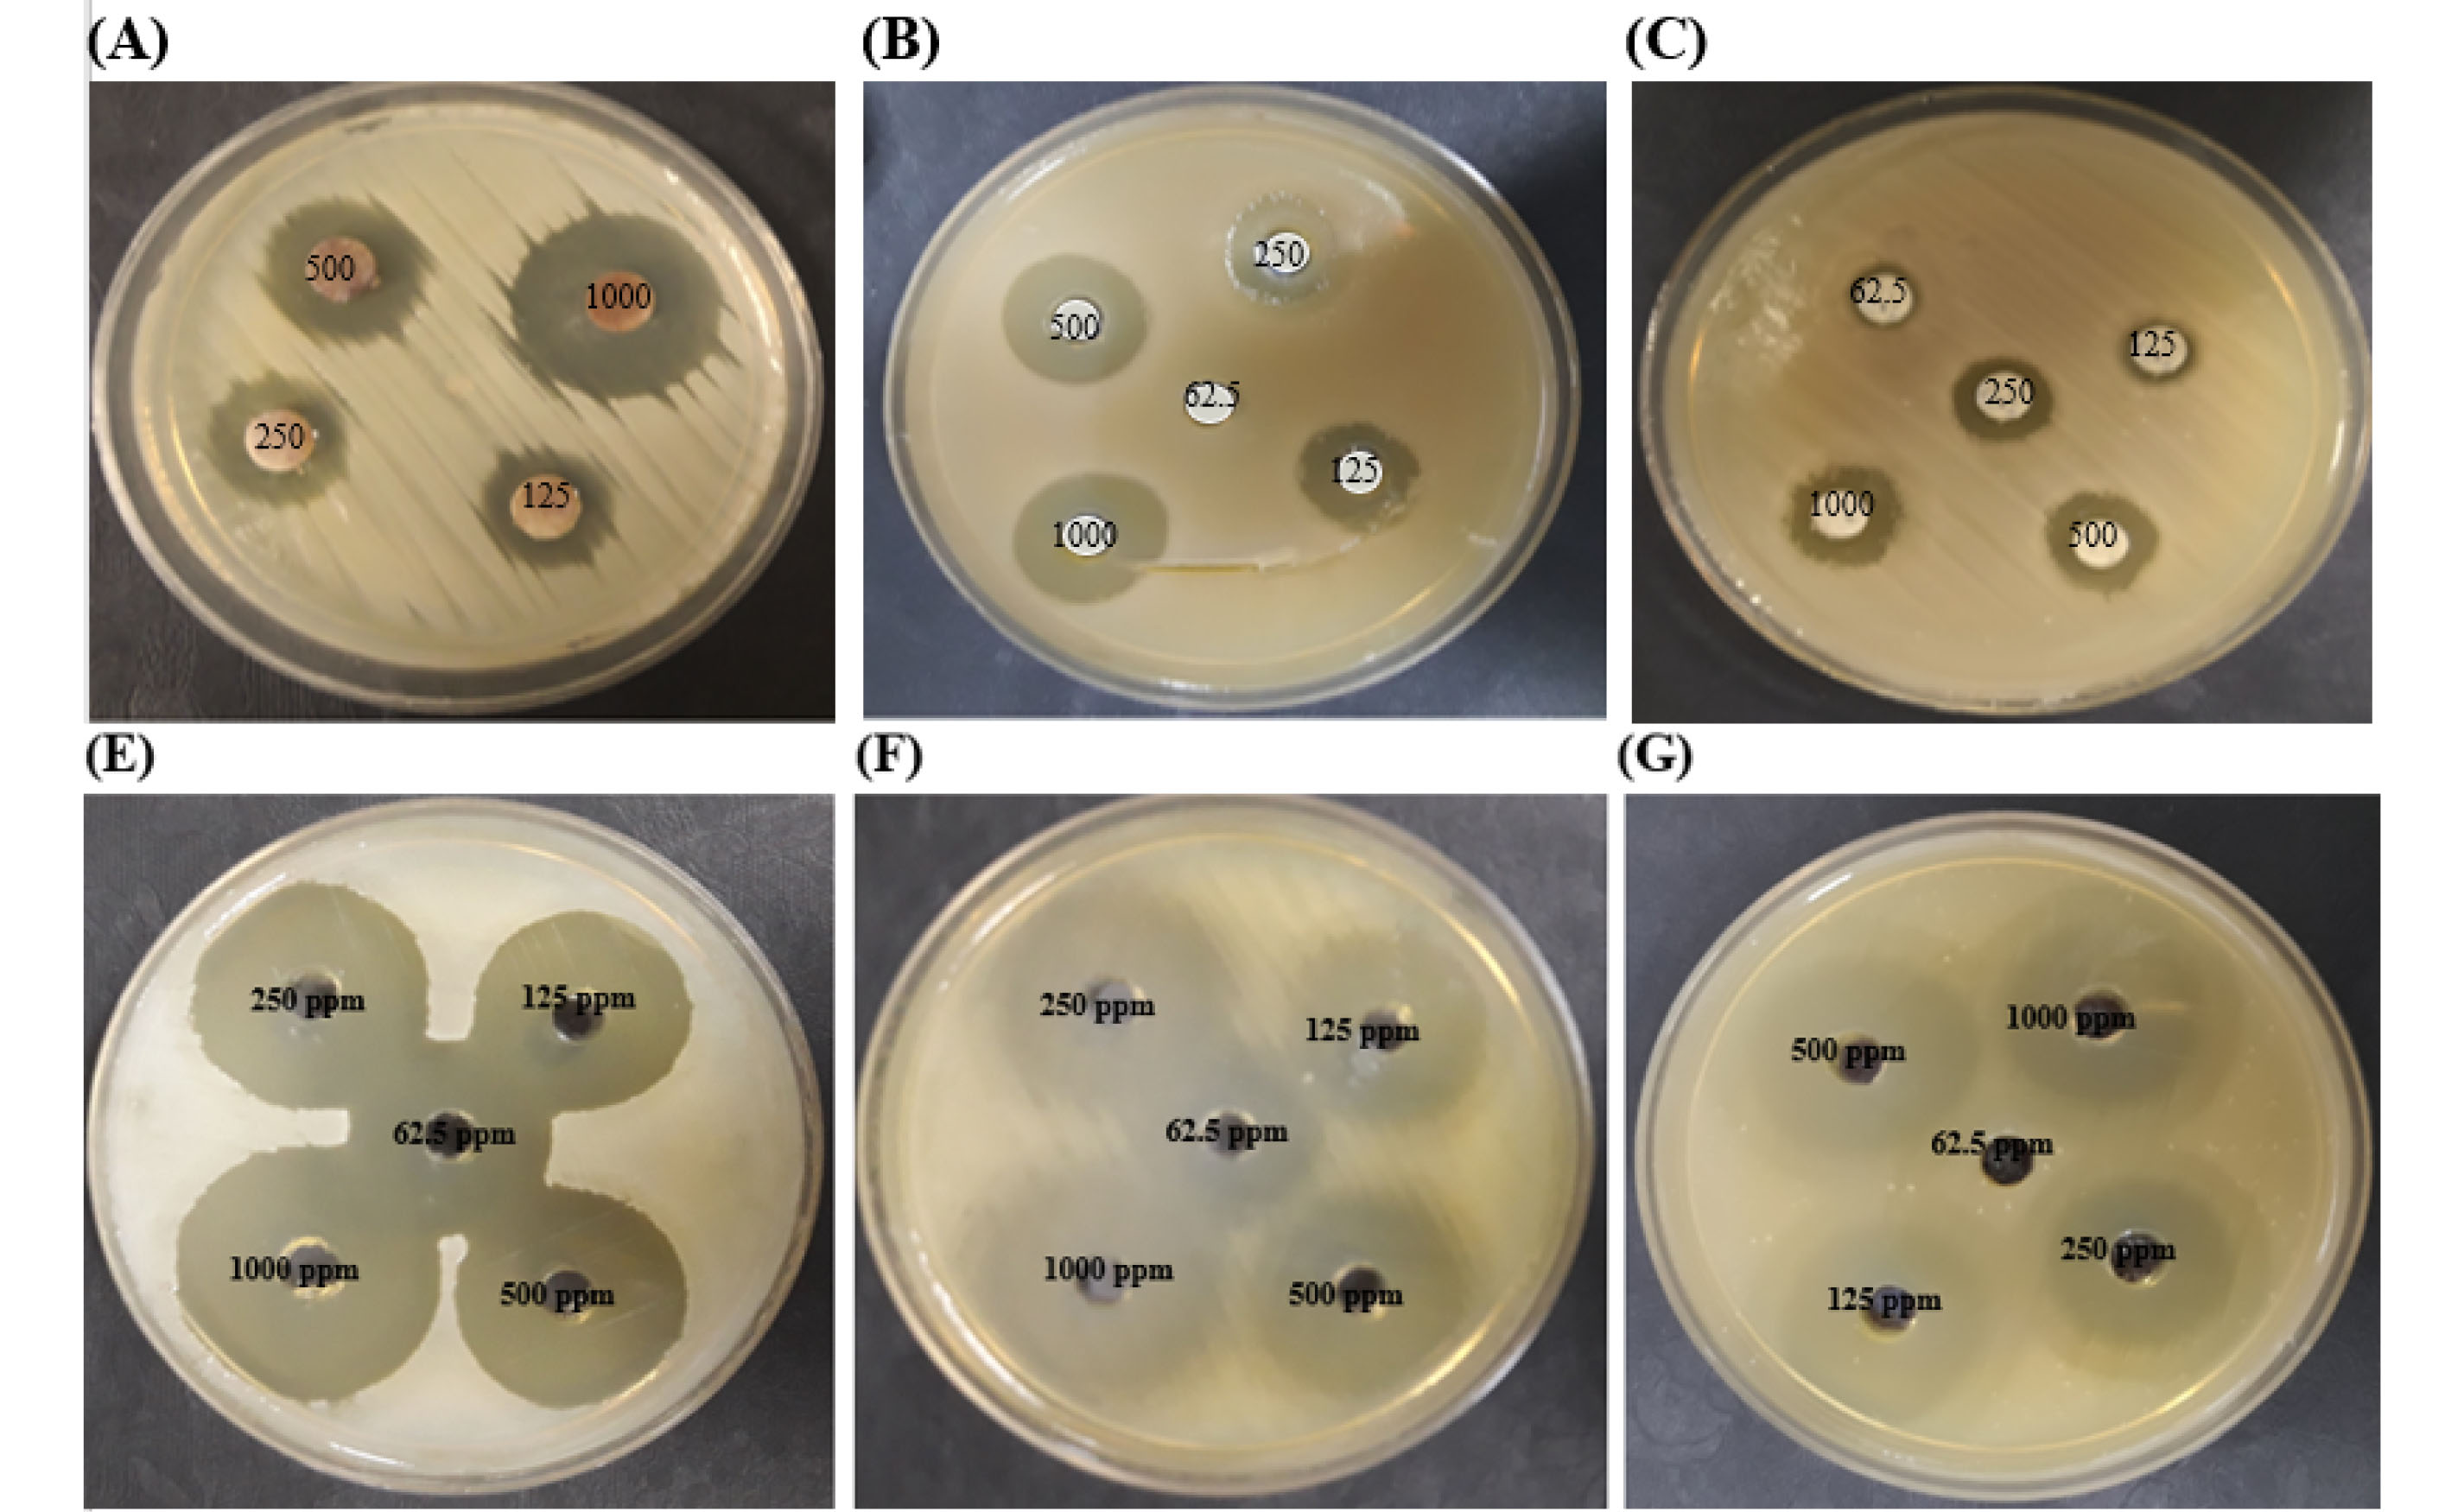
bi-12-33-g001
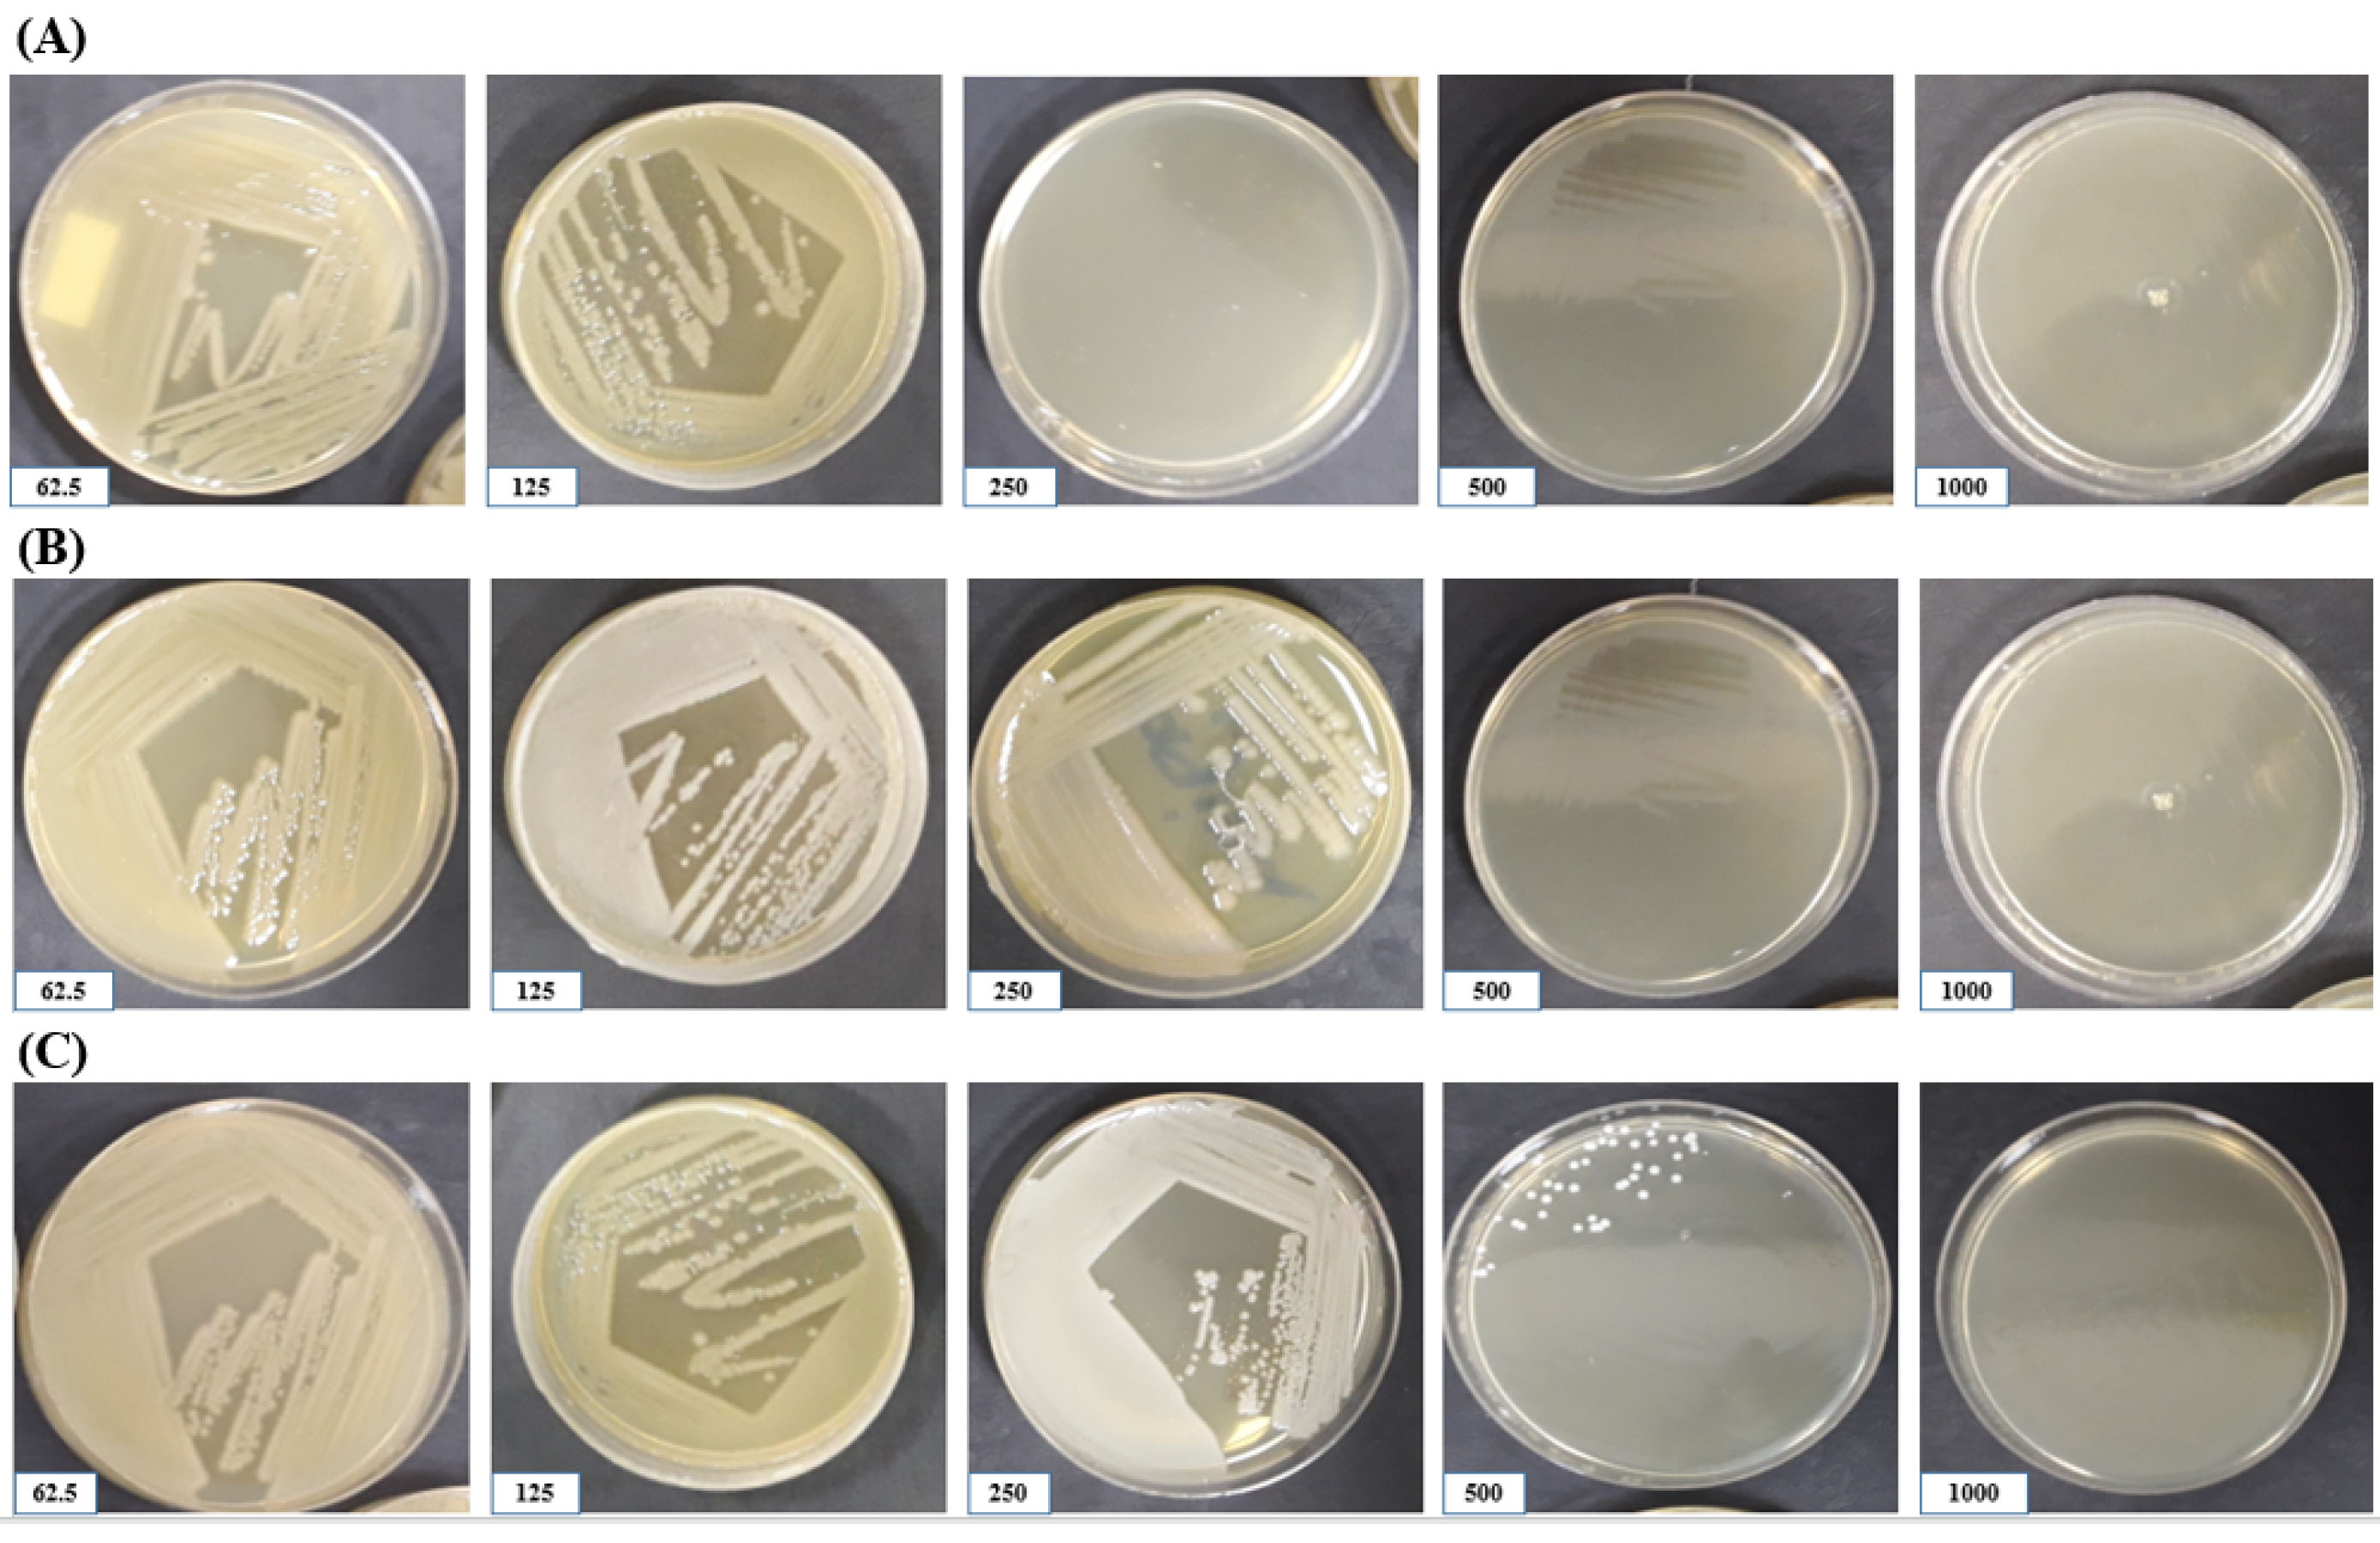
bi-12-33-g002

Bioimpacts. 12(1):33-42.
doi: 10.34172/bi.2021.22037
Original Research
Therapeutic effects of silver nanoparticle and L-carnitine on aerobic vaginitis in mice: an experimental study
Mozhgan Fatahi Dehpahni  , Khosrow Chehri *
, Khosrow Chehri *  , Mehri Azadbakht 1
, Mehri Azadbakht 1 
Author information:
Department of Biology, Faculty of Sciences, Razi University, Kermanshah, Iran
Abstract
Introduction:
Aerobic vaginitis (AV) is a type of vaginal infection that occurs at the reproductive age of women. In this study, we aimed to study the possible anti-AV therapeutic effects of silver nanoparticles (AgNPs) and L-carnitine (LC) in the mouse model.
Methods:
AV model was established by intra-vaginal inoculation of 108 CFU/mL Staphylococcus aureus and Escherichia coli (1:1) in adult NMRI mice. Susceptibilities of the bacteria were examined against AgNPs by inhibitory concentration (IC-50 and IC-90) and minimum biofilm inhibitory concentration (MBIC- 90) methods. The regimens therapy was intra-vaginal inoculation of AgNPs at MBIC- 90 and a daily injection of 250 mg/kg LC for two weeks. Mice were classified into healthy (control) and AV groups and then treated by LC, AgNPs, and AgNPs + LC. The vaginal smears were taken daily and tissue sections were prepared using the hematoxylin and eosin (H & E) method.
Results:
Minimum inhibitory concentrations (MICs) of AgNPs for E. coli, S. aureus, and their mixture were 250, 125, and 500 ppm, and their MBIC-90% were 500, 250, and 1000 ppm, respectively. The estrus cycle of mice treated with co-administration of AgNPs and LC was similar to the control group (P < 0.05). The results of histology also showed that infected mice were treated with AgNPs and LC, simultaneously.
Conclusion:
Single bacteria are more sensitive than their mixed model to these NPs. Co-administration of AgNPs as an antibacterial agent and LC as an antioxidant agent can treat AV in the infected mice.
Keywords: Aerobic vaginitis, Staphylococcus aureus, Escherichia coli, Metal nanoparticle, L-carnitine
Copyright and License Information
© 2022 The Author(s)
This work is published by BioImpacts as an open access article distributed under the terms of the Creative Commons Attribution License (
http://creativecommons.org/licenses/by-nc/4.0/). Non-commercial uses of the work are permitted, provided the original work is properly cited.
Introduction
The vagina has a stable environment containing a variety of microorganisms, especially lactobacilli. These bacteria play a key role in vaginal health by producing H2O2, bacteriocin, and lactic acid. Imbalance in the microbial population increases the number of pathogenic bacteria compared with lactobacilli and causes vaginal infection. This infection is one of the most common genital infections in women that is often ignored. In addition to the three prevalent cases, candidiasis, trichomoniasis, bacterial vaginosis, another uncommon status can change vaginal health.
1
The most mysterious and frequent reason is aerobic vaginitis (AV), introduces in an article in 2002.
2
The AV is determined by inflammation in the vagina, increased rate of aerobic bacteria, and decreased amounts of lactobacilli.
3
In the patient vaginal swap, some aerobic bacteria are often grown in the culture media, including Staphylococcus aureus and Escherichia coli.
4
AV is frequently diagnosed incorrectly as bacterial vaginosis that can lead to failures in treatment and strict complications, like infertility, preterm delivery, pelvic inflammatory disease, chorioamnionitis, miscarriage, and membranes premature rupture.
5
Up to now, there are no standard clinical therapeutics for treating the patient with AV.
6
Long and frequent consumption of antibacterial agents leads to side effects like antibiotic resistance, disrupt the balance of vaginal flora, and secondary infection.
7
This infection needs therapy method that targets the main factors of AV such as bacterial agents and inflammation.
1
Gene mutation, changing environmental status, and pollution cause the emergence of multidrug-resistant bacteria. To overcome this difficulty researchers, think about developing medicines for the treatment of these infections. Many nanomaterials are efficient in interacting and inhibiting bacterial infections.
8
Of these, silver nanoparticles (AgNPs) have played a great bactericidal role against a large number of bacteria.
9
Materials and compounds based on silver have historically been used as a disinfectant.
10
AgNPs react with different target structures of bacteria such as cell wall, lipids, proteins, enzymes, DNA, and plasmid and on the other hand, bacteria do not resist them.
11,12
In the last decade, countless NPs have been developed with diverse applications. Although these substances improve the quality of life, attention to their toxic and harmful effects on health is very important.
13
Various studies have been performed on the toxicity of metal NPs particularly AgNPs and there is general agreement that exposure to these substances has cytotoxicity and genotoxicity effects, leads to increased oxidative stress, production reactive oxygen species,
14
and apoptotic.
15
Therefore, it is necessary to find solutions for the reduction of the toxic effects of AgNPs. L-carnitine
14
is a small water-soluble molecule that plays an important role in lipid metabolism. The presence of this substance is necessary for the active transfer of fatty acid from the cytosol to the mitochondrial matrix.
16
It has antioxidant effects and plays a role in clearing free radicals from different sites of the cell.
17
LC can eliminate the effects of using AgNPs such as apoptosis and oxidative stress.
18
In addition, LC plays a major role in controlling inflammation and improving inflammatory diseases by reducing and suppressing inflammatory and pro-inflammatory cytokines.
19
Therefore, the use of this substance along with AgNPs may be appropriate to remove the side effects of AgNPs and the inflammation caused by AV. We established an AV model in adult female NMRI mice by intra-vaginal inoculation of equal ratio E. coli and S. aureus. For the first time, we tested the effect of AgNPs, as a potential antibacterial agent, against a mixture of E. coli and S. aureus, their biofilm, AV infection in patient mice. LC applied to remove tissue damage caused by infection and AgNPs treatment.
Materials and Methods
The AgNPs solution in size of 20 nm at 2000 ppm concentration purchase from the Persia Payam company of Hamadan, Iran, and kept at a temperature of 25°C in a dark place. LC hydrochloride was ordered from Sigma Aldrich. The Tryptic soy broth and Müller-Hinton media were provided from Merck Company, Germany. Blood agar, Mannitol salt agar, Eosin methylene blue 4, triple sugar iron agar (TSI), Simmons citrate agar, sulfide indole motility (SIM), Methyl red (MR), Urea agar, Phenylalanine agar, and Lysine agar media have provided.
Sample collection and bacterial strains
In this experimental study, pathogenic S. aureus and E. coli species were taken from infected women who were appended to the Moatazedi hospital in Kermanshah, Irandue to vaginitis and had typical symptoms of the infection. Samples of vaginal smear were taken with the help of sterilized swabs, and were culturedon EMB (for gram-negative bacteria) and blood agar (for gram-positive) media and incubated for 24 hours at 37°C. After incubation, other tests, including gram staining to detect Gram-positive and negative bacteria, E. coli and S. aureus differential tests. To identify E. coli, green colonies grown on EMB medium were isolated and TSI, Simon Citrate, SIM, MR, urease, phenylalanine, and lysine tests were performed for them. Catalase, coagulase, DNAase, and mannitol tests were performed to identify S. aureus.
20
E. coli ATCC 25922 and S. aureus ATCC 25923 were purchased from the Iranian Scientific and Industrial Research Company (IROST) and used in this research as standard bacterial strains.
Bacterial susceptibility to AgNPs by disk diffusion
The disk diffusion method was used to evaluate bacterial susceptibility to antibiotics and AgNPs based on the Clinical and Laboratory Standards Institute (CLSI).
21
For this purpose, after the preparation of microbial suspension according to standard 0.5-McFarland, the bacteria were cultured on Müller-Hinton agar medium under sterile conditions. Then, antibiotics and sterile disks, containing different concentrations of AgNPs diluted with 5% dimethyl sulfoxide (DMSO), with approximately 6 mm diameter was placed on the culture medium. After 24 hours incubation at 37°C, the inhibitory zone diameter was calculated using a ruler. Because there are no standard antibiotics for treating the AV, so antibiotics were not used to treat the infected mice. All experiments were repeated three times and their averages were reported.
Minimum inhibitory concentration (MIC)8 and minimum bactericidal concentration (MBC)
To determined MIC and MBC, the microdilution method was used in 96-well microplates based on the CLSI. First of all 100 µL of Müller-Hinton broth medium was poured into a row of microplate wells. The first well was mixed with 100 µL of the highest concentration of AgNPs (2000 ppm) and then serial dilution was applied until well 11. The concentration of NPs in the wells was 1.95 to 1000 ppm. Wells of 11 and 12 were considered as negative and positive controls. Then, a ratio of 1:10 of S. aureus, E. coli, and an equal combination of both bacteria (1:1) suspension with McFarland 0.5 concentration was added to all wells, except in the 11th well. Microplates were kept in a shacked incubator for 24 hours at 37°C. The optical density
22
was read by an ELISA reader at 600 nm. The contents of two wells before and after the well that was not turbid, 50 µL was removed and transferred to the Müller-Hinton agar medium. The MBC is the lowest concentration of AgNPs that reduces the viability of the initial bacterial inoculum by ≥ 99.9% and no bacteria have grown on the Müller-Hinton agar medium. All experiments were repeated three times and their averages were reported.
23
This test was also used to investigate the possible effect of LC on bacterial growth.
Anti-biofilm effect of AgNPs
The ability of biofilm formation by E. coli, S. aureus, and the combination of them were determined by the microtiter plate method. To investigate the anti-biofilm effects of AgNPs, 180 µL of TSB medium was added to all microplate wells and then 10 µL of different dilutions of AgNPs were added to each well. Finally, each well was added 10 µL of the bacterial suspension so that the volume of wells reached 200 µL. Thus, AgNPs were prepared at concentrations of 15.62, 31.25, 62.5, 125, 250, 500, and 1000 ppm. The first-row microplate wells contained 180 µL of TSB medium, 10 µL of 5% DMSO, and 10 µL of bacterial suspension, and blank wells contained only 200 µL of TSB medium without bacteria and NPs. The microplates were incubated at 37°C overnight. After 24 hours incubation, the microplates were exited from the incubator, their contents were slowly removed, and the wells were washed three times with phosphate-buffered saline (PBS). For biofilm fixation, 200 µL of 95% ethanol was applied for 15 minutes and then stained with 200 µL of 0.2% crystal violet for 10 minutes. After emptying the wells, they were washed and dried several times with PBS. 200 µL of 0.33% glacial acetic acid was added as the solvent and after 15 minutes absorbance of the wells was read using ELISA Reader at 600 nm. Finally, the percentage of biofilm inhibition was calculated. All experiments were repeated three times and their averages were reported.
24,25
% of biofilm inhibition = {(Control OD600 nm– Test OD600 nm) / Control OD600 nm} × 100
Animals
Adult female NMRI mice (6-8 weeks old) were ordered from the Pasteur Institute of Iran. To determine how much AgNPs are used in mice, LD50 (Lethal Dose 50%)must be determined, which is essential at the beginning of the experiment.
26
In our study, AgNPs were purchased as a solution prepared at a concentration of 2000 ppm. AgNPs were diluted in DMSO to create the doses required to detect the LD50. The LD50 of AgNPs that causes the death of 50% of the mice (n= 5 per group) was determined by intraperitoneal injection with three dose levels of 0.03 μg/kg (1000 ppm), 0.45 μg/kg (1500 ppm), and 0.06 μg/kg (2000 ppm). Mice were observed for body weight, body temperature, mortality, clinical signs such as diarrhea, the number of dead mice, seizures, and drowsiness was monitored for 14 days. But, our results of this test showed that NPs solution did not have the LD50 in the highest concentration (2000 ppm) for two weeks. In order to reduce the inflammatory effects of infection and AgNPs, a daily injection of 250 mg/kg LC was used.
27
Mice divided into 8 groups (n= 7 per group): (1) The control group, which received only water and food, (2) LC group, in this group there were healthy and non-infected mice receiving 250 mg/kg daily injection LC for two weeks; (3) AgNPs group, healthy and non-infected mice that received 1000 ppm AgNPs intra-virginally for two weeks. (4) AgNPs + LC group: In this group were healthy and non-infected mice that were given simultaneously for two weeks, daily injection of 250 mg/kg LC, and inoculation of 1000 ppm AgNPs. (5) AV group (AV): mice in this group were infected by a 1:1 ratio of both E. coli and S. aureus and received no treatment. (6) AV + LC: In this group were mice infected with an equal proportion of both bacteria and they received a daily injection of 250 mg/kg of LC for two weeks. (7) AV + AgNPs: In this group were infected mice with an equal proportion of both bacteria and received 1000 ppm AgNPs for two weeks. (8) AV + LC + AgNPs: In this group were infected mice that were infected with an equal proportion of both bacteria and received 250 mg/kg LC and 1000 ppm AgNPs for two weeks.
Aerobic Vaginitis (AV) model in mice
To create a vaginitis model, E. coli and S. aureus were cultured in Lauria Bertani broth medium and incubated at 37°C for 24 hours. After incubation, the media containing bacteria were centrifuged at 5000 rpm for 20 minutes and washed with normal saline. Finally, the bacterial count reached 108 CFU/mL. AV model was performed by intra-vaginal inoculation, with a combination of both bacterial suspensions prepared in a 1: 1 ratio. To inoculate the mice, they were fixed by hand and the bacterial suspension was inserted into the vaginal cavity. To stabilize infections in mice after 48 hours of primary inoculation, a secondary inoculation was applied.
28
Determination of the estrus cycle of mice
The estrus cycle is the reproductive cycle in them, and changes in this cycle indicate physiological and anatomical changes. This cycle is shorter in rodents, especially in mice, and making it suitable for genital studies such as infection and medication assessment. The different stages of the estrus cycle are determined by the ratio of different types of cells observed in vaginal discharge. In this study, vaginal smears were obtained from mice of all groups, and the sampling period was two weeks. The specimens were taken between 7 and 8 am using 50 µL of normal slain, after fixation stained by crystal violet, examined by a light microscope, and the estrus phase was detected according to the ratio of cells. The proestrus stage consisted of two types of horny and epithelial cells, the estrous stage with one cell type, which is the horny cell, was diagnosed, the metestrus stage was detectable with the horny cells and leukocytes, and the diestrus stage with a population includes leukocytes.
27
Histological studies
At the end of the experiments, mice were sacrificed by cervical dislocation. The vaginal tissue of mice was isolated, and placed in a Bouin fixative solution. Histological stages were dehydrated with different degrees of ethanol, clarified with xylene, embedded in paraffin. From the tissue blocks, sections with 5 μm diameter were made by Microtome, and stained with hematoxylin and eosin.
29
Statistical analysis
Descriptive statistics, mean, standard deviation and graph were used to describe the data. Data were analyzed using SPSS version 26. Differences between OD values and means were compared using a one-way analysis of variance (ANOVA) and the significance level was set at P < 0.05.
Results
Bacterial identification
Escherichia coli and S. aureus can be easily detected by microscopic examination and biochemical characteristics. E. coli after growth on EMB medium formed distinctive metallic green colonies. Colonies of S. aureus on blood agar medium had zones of clear beta-hemolysis that surrounded Colonies. Microscopic examination and chemical tests also used for bacterial identification that proved the existence of E. coli and S. aureus andlisted in Table 1.
Table 1.
Biochemical examination and identification of Escherichia coli and Staphylococcus aureus
|
Characteristics
|
E. coli
|
| Gram staining |
negative |
| Shape |
Rods |
| Motility |
Positive |
| Oxidase |
Negative |
| Methyl red |
Positive |
| Voges-Proskauer |
Negative |
| Indole |
Positive |
| Citrate |
Negative |
| Urease |
Negative |
| Hydrogen sulfide |
Negative |
| Gas |
Positive |
| Lysine |
Positive |
| Phenylalanine deaminase |
Negative |
| Characteristics |
S. aureus
|
| Gram staining |
Positive |
| Shape |
Cocci |
| Catalase |
Positive |
| Coagulase |
Positive |
| Hemolysis |
Positive-Beta |
| Motility |
Negative |
| Oxidase |
negative |
| DNase |
Positive |
| Mannitol |
Positive |
Bacterial susceptibility to AgNPs by disk diffusion
The disk diffusion method was utilized to determine the antimicrobial effects of AgNPsagainst two types of bacteria, gram-positive and negative, were selected in our study. AgNPsexhibited antimicrobial activity against the standard and pathogenic cultures of E. coli, S. aureus, and their mixture at 62.5, 125, 250, 500, and 1000 ppm of AgNPs. The Effective concentration of AgNPson standard and pathogenic strains of E. coli, S. aureus, and their combination were reported in Table 2. The inhibitory activity of AgNPsstarted at 62.5 ppm with an inhibition zone of 9.65 and 9 mm for E. coli ATCC 25922 and S. aureus ATCC 25923, respectively, 125 ppm with an inhibition zone of 9.25, 11.45, and 9.7 mm for pathogenic types of E. coli, S. aureus, and the combination of E. coli ATCC 25922/S. aureus ATCC 25923, and 250 ppm with an inhibition zone of 9.2 mm for the mixture of E. coli /S. aureus that isolation from the infected vagina. Therefore, AgNPshave efficient antimicrobial properties and their effects against the mixture forms of E. coli /S. aureus was lower than the single situation of the bacteria (Fig. 1).
Table 2.
Effect of silver nanoparticles on pathogenic and standard Staphylococcus aureus, Escherichia coli, and combination of them
|
Bacterial Strains
|
Concentration of Ag NPs (ppm)
|
|
62.5
|
125
|
250
|
500
|
1000
|
|
S. aureus ATCC 25923
|
9.01±0.14 |
12.55±0.49 |
15.1±0.14 |
18.45±0.49 |
19.7±0.28 |
|
Pathogenic S. aureus
|
0 |
11.45±0.49 |
15.05±0.21 |
17.45±0.64 |
19.15±0.07 |
|
E. coli ATCC 25922
|
9.65±0.21 |
12.76±0.33 |
15.2±0.42 |
19.35±0.49 |
20.55±0.64 |
|
Pathogenic E. coli
|
0 |
9.25±0.49 |
13.8±0.42 |
15.25±0.49 |
18.25±0.49 |
|
Standard E. coli & S. aureus
|
0 |
9.7±0.28 |
13.3±0.57 |
15.15±0.35 |
17.01±0.14 |
|
Pathogenic E. coli & S. aureus
|
0 |
0 |
9.2±0.42 |
12.17±0.1 |
16.25±0.49 |
Zone of inhibition (mean ± standard deviation) measured around 125, 250, 500, and 1000 ppm impregnated disks with the nanoparticles.
Fig. 1.
Antimicrobial activities of different concentrations of silver NPs in 20 nm diameter toward S. aureus (A), E. coli (B), and their mixture (C) isolated from vaginitis. Antibacterial properties of different concentrations of these NPs against S. aureus ATCC 25923 (E), E. coli ATCC 25922(F), and their combination (G).
.
Antimicrobial activities of different concentrations of silver NPs in 20 nm diameter toward S. aureus (A), E. coli (B), and their mixture (C) isolated from vaginitis. Antibacterial properties of different concentrations of these NPs against S. aureus ATCC 25923 (E), E. coli ATCC 25922(F), and their combination (G).
Inhibitory concentration of silver nanoparticles
MIC is the lowest concentration of an antibacterial agent that inhibits the visible growth of a bacteria after 24-hour incubation. IC-50 and IC-90 values are the concentration of AgNPs required for 50% and 90% bacterial growth inhibition. According to the IC-50 and IC-90 values that are exhibited in Table 3, the IC-50 values of the AgNPs for standard and pathogenic E. coli are 93.58 and 105.59 ppm, the IC- 50 values of the AgNPs for standard and pathogenic S. aureus are 43.48 and 141.63 ppm, and the IC- 50 values of the AgNPs for standard and pathogenic combination of E. coli/ S. aureus are 157.74 and 280.43 ppm, respectively. The IC-90 values of the AgNPs for standard and pathogenic E. coli are 200.11 and 215.12 ppm, the IC-90 values of the AgNPs for standard and pathogenic S. aureus are 168.32 and 336.19 ppm, and the IC-90 values of the AgNPs for standard and pathogenic combination of E. coli/ S. aureus are 381.35 and 681.23 ppm, respectively. The MIC of NPs for S. aureus ATCC 25923 and the pathogenic strain were 125, for E. coli ATCC 25922 and the pathogenic strain was 125 and 250, for the combination of standard and pathogenic S. aureus and E. coli at concentrations of were 250 and 500 ppm, respectively. MBC levels of AgNPs are higher than their MICs, indicating that higher concentrations are needed for killing the bacteria, which was 500, 250, and 1000 ppm for E. coli, S. aureus, and their mixture (Fig. 2). This antimicrobial activity of SNPs is shown significantly more on the mixed model on infection than the single forms of bacteria. The test also found that L-carnitine had no antimicrobial effect and did not inhibit bacteria.
Table 3.
The mean of minimum inhibitory concentration, IC50, and values of AgNPs against pathogens S. aureus, E. coli, and their mixture (ppm)
|
Bacterial Strains
|
IC- 50
|
IC- 90
|
MIC
|
MBC
|
|
S. aureus ATCC 25923
|
43.48 |
168.32 |
125 |
250 |
|
Pathogenic S. aureus
|
93.58 |
200.11 |
125 |
250 |
|
E. coli ATCC 25922
|
105.59 |
215.12 |
125 |
500 |
|
Pathogenic E. coli
|
141.63 |
336.19 |
250 |
500 |
|
Standard E. coli & S. aureus
|
155.74 |
318.35 |
250 |
500 |
|
Pathogenic E. coli & S. aureus
|
280.43 |
681.23 |
500 |
1000 |
IC-50: Minimum biofilm inhibitory concentration- 50%, IC-90: Minimum biofilm inhibitory concentration- 90%, MIC: Minimum inhibitory concentration, and MBC: Minimum bactericidal concentration
Fig. 2.
The lethal effects of different concentrations of AgNPs against S. aureus (A), E. coli (B), and their mixture (C) isolated from vaginitis.
.
The lethal effects of different concentrations of AgNPs against S. aureus (A), E. coli (B), and their mixture (C) isolated from vaginitis.
Anti-biofilm effect of AgNPs
The efficacy of AgNPs in inhibiting biofilm formation of S. aureus, E. coli, and the combination of both bacteria was tested in the concentration of 15.62–1000 ppm. As shown in Table 4, AgNPs inhibited the biofilm formation by S. aureus, E. coli, and their mixture. Biofilm inhibition occurred at up-MIC concentrations. The first step for evaluating the antibiofilm effect of AgNPs against a mixed modelof vaginitis was an assessment of mono- species of biofilm of E. coli and S. aureus susceptibility to this nanoparticle. Our results indicate that MBIC-90 values of the AgNPs for both standard and pathogenic E. coli is 500 ppm, the MBIC-90 values of the AgNPs for standard and pathogenic S. aureus are 250 and 500 ppm, and the MBIC-90 values of the AgNPs for standard and pathogenic combination of E. coli/ S. aureus are 500 and 1000 ppm, respectively.
Table 4.
The concentration of silver nanoparticles that inhibits 50 and 90 % of pathogenic Escherichia coli, Staphylococcus aureus, and their combination biofilm formation
|
Bacterial strains
|
MBIC- 50
|
MBIC- 90
|
|
S. aureus ATCC 25923
|
62.5 (ppm) |
250 (ppm) |
|
Pathogenic S. aureus
|
125 (ppm) |
500 (ppm) |
|
E. coli ATCC 25922
|
125 (ppm) |
500 (ppm) |
|
Pathogenic E. coli
|
250 (ppm) |
500 (ppm) |
|
Standard E. coli & S. aureus
|
250 (ppm) |
500 (ppm) |
|
Pathogenic E. coli & S. aureus
|
250 (ppm) |
1000 (ppm) |
MBIC-50: Minimum biofilm inhibitory concentration- 50%, and MBIC- 90: Minimum biofilm inhibitory concentration- 90%
Determine the stages of the estrous cycle and compare it between different groups
Different stages of the estrous cycle were determined by staining of vaginal discharge and based on the type and proportion of cells observed in vaginal smears. The changes in different stages of the estrus cycle were similar to standard and pathogenic models. In terms of the duration of the proestrus phases, mice in the LC (P < 0.03), AgNPs (P < 0.0002), AV (P < 0.0005), AV + LC (P < 0.0001), and AV + AgNPs (P < 0.0004) groups showed a significant decrease compared to the control group. For estrus stage, mice in the AgNPs (P < 0.007), AV (P < 0.002), AV + LC (P < 0.028), and AV + AgNPs (P < 0.002) groups showed a significant decrease compared to the control group. For the duration of the metestrus, mice in the LC (P < 0.033) and AgNPs (P < 0.033) groups showed a significant increase compared to the control group. For the duration of the diestrus, mice in the AgNPs (P < 0.033), AV (P < 0.003), AV + LC (P < 0.015), and AV + AgNPs (P < 0.0003) groups showed a significant increase compared to the control. But in the LC + AgNPs and AV + LC + AgNPs groups, the estrus cycle duration was similar to the control group at all stages (Table 5).
Table 5.
Microscopy monitoring of estrus cycle in female NMRI mice (P: Pro-estrus, E: Estrus, M: Met-estrus, D: di-estrus)
|
|
|
Observation days
|
|
|
Groups of Mice
|
1
|
2
|
3
|
4
|
5
|
6
|
7
|
8
|
9
|
10
|
11
|
| 1 |
Control |
P |
P |
P |
E |
E |
E |
M |
M |
D |
D |
D |
| 2 |
LC |
P |
P |
E |
E |
M |
M |
M |
M |
D |
D |
D |
| 3 |
Ag NPs |
E |
M |
M |
M |
D |
D |
D |
D |
D |
D |
D |
| 4 |
Ag NPs + LC |
P |
P |
E |
E |
E |
E |
M |
M |
D |
D |
D |
| 5 |
AV |
M |
M |
D |
D |
D |
D |
D |
D |
D |
D |
D |
| 6 |
AV + LC |
P |
E |
M |
M |
D |
D |
D |
D |
D |
D |
D |
| 7 |
AV + Ag NPs |
M |
D |
D |
D |
D |
D |
D |
D |
D |
D |
D |
| 8 |
AV + LC + Ag NPs |
P |
P |
P |
E |
E |
E |
E |
M |
D |
D |
D |
LC group: in this group, there were healthy and non-infected mice receiving 250 mg/kg daily injection LC; AgNPs group: healthy and non-infected mice that received 1000 ppm AgNPs intra-virginally, AgNPs + LC group: healthy and non-infected mice that were given simultaneously daily injection of 250 mg/kg LC, and inoculation of 1000 ppm AgNPs, AV group (AV): infected mice with 1: 1 ratio of both E. coli and S. aureus, AV + LC: mice that infected and received a daily injection of 250 mg/kg of LC, AV + AgNPs: infected mice that received 1000 ppm AgNPs, AV + LC + AgNPs: infected mice that received 250 mg/kg LC and 1000 ppm AgNPs.
Macroscopic results of vaginitis
Clinical signs in groups were evaluated by investigating their vaginal appearance and were reported in Table 6. Based on the observations, AgNPs and LC in AV + LC, and AV + AgNPs groups did not improve the process of vaginal infection. These observations showed that co-administration of AgNPs and LC in group AV + LC + AgNPs led to the treatment of the infection.
Table 6.
Macroscopic results of AV vaginitis and its treatment
|
Signs
|
Groups
|
|
AV
|
AV + AgNPs
|
AV + LC
|
AV + AgNPs + LC
|
| Kind of discharge |
White and often Colorless, yellow and sometimes with blood, foul smell |
White and often Colorless, yellow, foul smell |
White and often Colorless, yellow, foul smell |
Normal |
| Inflammation of the tissue |
Too much |
Too much |
Much |
- |
| Swelling of the vaginal area |
Too much |
Much |
Much |
-
|
| Tissue color |
Red |
Red |
Red |
Normal |
| Leukocyte count |
Too much |
Too much |
Too much |
Normal |
AV, Aerobic vaginitis; AgNPs, Silver nanoparticles; LC, L-carnitine.
Vaginal histology results
Histological studies were performed based on the slides obtained from 4 to 5 μm sections of vaginal tissue stained with hematoxylin and eosin method. In this regard, some features were investigated, including leukocyte levels, hyperplasia, hyperemia, inflammation, keratinization of the epithelium, and order in the connective tissue. In the control group (Fig. 3A) was indicated that the level of leukocytes and blood vessels was normal, there was no sign of hyperplasia, bleeding, and inflammation in the tissue, stratified squamous epithelium, and its density were normal, and connective tissue has been regular. In the AgNPs group (Fig. 3B) was shown that the level of leukocytes and blood vessels increased in tissue. Hyperplasia, inflammation, and epithelial keratinization was occurred by NPs in tissue, and not regular in the connective tissue. The LC group (Fig. 3C) was shown that leukocyte levels were normal. The blood vessels were increased in this group. Blood-rich was also seen in some areas. In the tissue, there were signs of bleeding, inflammation, and keratinization of the epithelium, and the connective tissue was not arranged. In the AgNPs + LC group (Fig. 3D) was indicated that leukocyte, blood vessels, epithelial density, epithelial keratinization, and regularity of connective tissues were normal. In the AV group (Fig. 4A), the rate of inflammation was very high and leukocytes increased in tissue, blood vessels and blood-rich tissue occurred. The epithelial density was decreased, and the order of the cells in the connective tissue was destroyed. In AV + AgNPs group (Fig. 4B) levels of leukocyte, blood vessels, inflammation, blood-rich, hyperplasia, and bleeding occurred in the tissue. The arrangement of cells in the connective tissue was destroyed. In AV + LC group (Fig. 4C) the number of leukocytes and inflammation was high, hyperplasia, increased blood vessels, bleeding and blood-rich decreased epithelial density, and increased keratinization occurred and the arrangement of cells in the connective tissue was degraded. The level of leukocytes and blood vessels in AV + AgNPs + LC group was normal (Fig. 4D); no sign of hyperplasia, bleeding, and inflammation in the tissue and stratified squamous epithelium was observed, density of epithelium layer was normal and connective tissue was regular. The results of the experiment showed that there was no treatment in the AV+LC and AV + AgNPs. However, in the groups treated with both the LC and AgNPs, AV + AgNPs + LC group, were completely improved.


Fig. 3.
Histology examination of healthy mice vaginal tissue: In the control group (A) was indicated that the level of leukocytes and blood vessels was normal, there was no sign of hyperplasia, bleeding, and inflammation in the tissue, stratified squamous epithelium and its density were normal and connective tissue has been regular. AgNPs group (B) was shown that the level of leukocytes and blood vessels increased in tissue. Hyperplasia, inflammation, and epithelial keratinization were occurred by NPs in tissue, and not regular in the connective tissue. In the LC group (C) was shown that leukocyte levels were normal. The blood vessels were increased in this group. Blood-rich was also seen in some areas. In the tissue, there were signs of Bleeding, inflammation and keratinization of the epithelium, and the connective tissue was not arranged. In the AgNPs + LC group (D) was indicated that leukocyte, blood vessels, epithelial density, epithelial keratinization and regularity of connective tissues were normal. AV: Aerobic vaginitis, AgNPs: Silver nanoparticles, and LC: L carnitine. Signs on Figures; VM: Vaginal mucosa, LP: Lamina propria.
.
Histology examination of healthy mice vaginal tissue: In the control group (A) was indicated that the level of leukocytes and blood vessels was normal, there was no sign of hyperplasia, bleeding, and inflammation in the tissue, stratified squamous epithelium and its density were normal and connective tissue has been regular. AgNPs group (B) was shown that the level of leukocytes and blood vessels increased in tissue. Hyperplasia, inflammation, and epithelial keratinization were occurred by NPs in tissue, and not regular in the connective tissue. In the LC group (C) was shown that leukocyte levels were normal. The blood vessels were increased in this group. Blood-rich was also seen in some areas. In the tissue, there were signs of Bleeding, inflammation and keratinization of the epithelium, and the connective tissue was not arranged. In the AgNPs + LC group (D) was indicated that leukocyte, blood vessels, epithelial density, epithelial keratinization and regularity of connective tissues were normal. AV: Aerobic vaginitis, AgNPs: Silver nanoparticles, and LC: L carnitine. Signs on Figures; VM: Vaginal mucosa, LP: Lamina propria.

Fig. 4.
Pathogenic vaginal tissue sections of infected mice. AV mouse model without treatment (A), AV mice treated with 1000 ppm of AgNPs every day (B), AV mice treated with daily injection 250 mg of LC for two weeks (C), AV mice treated with 250 mg/kg LC and 1000 ppm AgNPs for two weeks, simultaneously (D). AV mice had pathological sections such as inflammation, hyperplasia, desquamative epithelial mucosa, and high level of leukocytes. These symptoms were more severe in AgNPs-treated mice and less severe in LC-treated mice. The mice in the AV + AgNPs + LC group had the similar sections to the health mice. AV: Aerobic vaginitis, AgNPs: Silver nanoparticles, and LC: L carnitine. Signs on Figures; VM: Vaginal mucosa, LP: Lamina propria.
.
Pathogenic vaginal tissue sections of infected mice. AV mouse model without treatment (A), AV mice treated with 1000 ppm of AgNPs every day (B), AV mice treated with daily injection 250 mg of LC for two weeks (C), AV mice treated with 250 mg/kg LC and 1000 ppm AgNPs for two weeks, simultaneously (D). AV mice had pathological sections such as inflammation, hyperplasia, desquamative epithelial mucosa, and high level of leukocytes. These symptoms were more severe in AgNPs-treated mice and less severe in LC-treated mice. The mice in the AV + AgNPs + LC group had the similar sections to the health mice. AV: Aerobic vaginitis, AgNPs: Silver nanoparticles, and LC: L carnitine. Signs on Figures; VM: Vaginal mucosa, LP: Lamina propria.
Discussion
Vaginal infection is one of the most common clinical problems in women that requires timely diagnosis and treatment, otherwise, it will become a source of infection for their partner and infants. According to studies, bacteria are the most common microorganisms isolated from women, especially infertile women.
11,30,31
In this study, we applied an AV model in mice by intra-vaginal inoculation of a ratio proportion of E. coli and S. aureus. It is a polymicrobial infection caused by two or more aerobic bacteria in the vagina.
32
AV is highly prevalent in women and has the potential to transmit sexually so require timely identification and treatment, otherwise becoming a major problem in maternal and fetal health.
31
AV is an infectious and inflammatory disease so it requires a combination of medicines to target various microbial agents and inflammation-causing infections. Therefore, no standard treatment has been provided for this disease.
1
In this study, we used a combination of two substances, AgNPs to attack bacterial agents and LC to remove the side effects of AgNPs and to improve inflammation caused by the disease.
The mechanism of AgNPs was investigated by Li et al.
31
They showed that the NPs leak proteins and glucose, inactivate the respiratory chain, damage the cell wall structure, create large and small holes in the cell membrane, decrease the activity of some membrane enzymes, and ultimately cause bacterial cell death. Xu et al showed that the addition of AgNPs to the culture medium containing E. coli inhibited the growth of these bacteria and that the antibacterial activity was higher at 37°C.
32
In addition, higher antibacterial effects were indicated for AgNPs against E. coli, S. aureus, S. epidermidis, and S. marcescens bacteria compared to Cu and TiO2NPs.
33
Kim and colleagues in 2011 showed that these AgNPs have strong antibacterial activity against S. aureus and their MIC is 100 μg/mL.
34
Namasivayam et al in 2013 investigated the effect of AgNPs on bacterial biofilm and showed that these substances have potent ant-biofilm effects and can reduce the biofilm induced by S. aureus 84% at a concentration of 100 μg/mL.
22
The results of our studies also showed that AgNPs are highly capable of removing planktonic states as well as biofilm induced by E. coli, S. aureus, and their mixture. Based on the results of our study, the MIC of the NPs for S. aureus, E. coli, and their combination were 125, 250, and 500 ppm, respectively, and their biofilm inhibition reached over 90% at concentrations of 250, 500, and 1000 ppm, respectively.
Along with the strong antibacterial activity of AgNPs, studies have shown that exposure to these substances has harmful effects on mammalian cells. This toxicity depends on the size and dosage of NPs. Among the side effects of exposure to NPs include changes in blood factors, enzymatic activity, and behavior of laboratory animals.
35,36
The most important destruction mechanism of these substances involves the formation of reactive oxygen species and oxidative stress.
18
Chen and colleagues in 2015 were the first to investigate tissue damage caused by intra-vaginal inoculation of AgNPs in rabbits. They have shown that these substances not only accumulate in the vagina and destroy it, but also affect the surrounding tissues.
37
These substances can also affect the reproductive system and cause hormonal changes as reproductive toxins and changes in the menstrual cycle, ovulation, and fertility.
38
Our studies also showed that vaginal tissue was severely damaged in mice intra-vaginal inoculated with AgNPs. On the other hand, the estrous cycle of mice that received NPs was in an abnormal state, in the metestrus and diestrous phases. Therefore, the daily injection of LC was used to eliminate the side effects of AgNPs and inflammation caused by infection.
LC has the capacity to strengthen the antioxidant and mitochondrial defense system and can remove free radicals from various cellular sites.
17,39
It has a high ability to maintain the oxidative and metabolic state of the female reproductive system and is involved in improving fertility.
40
Liu and colleagues in 2015 showed that high levels of LC increase mitochondrial antioxidant capacity and decrease free radicals.
17
Their studies have shown that co-administration of AgNPs and LC can eliminate the toxic effects of NPs and eliminate the oxidative stress caused by the use of AgNPs. In addition, these substances may be effective in improving inflammatory diseases by suppressing inflammatory and pro-inflammatory cytokines.
19,30
Our studies also showed that in groups of mice that received a combination of AgNPs and LC, the estrous cycle of mice and their tissues were in a normal and similar state to the control group.
Conclusion
AV is a serious, and sexually transmitted disease that requires timely and accurate diagnosis and treatment. The treatment of these types of infections is complex and requires a combination of medicines that target the bacteria and inflammation agents of the infection at the same time. The results showed that the two-bacterial mixture (AV model) was more resistant to single-bacterial modes and required a higher concentration of AgNPs to inhibit it. Evidence from this study showed that co-administration of AgNPs, as an antibacterial agent, and LC, as an anti-inflammatory and antioxidant agent, led to the treatment of the disease in infected mice. There was no evidence of improvement in infection caused by the single use of either medicine alone. Interaction between AgNPs and LC resulted in the treatment of AV, regulation of the estrous cycle of mice, and removal of symptoms caused by the infection. Therefore, co-administration of these two substances can be used as a treatment for this infection.
Acknowledgments
This paper emanates from the MSc thesis of the first author submitted to the Department of Biology, Faculty of Science, Razi University 67149-67346, Kermanshah, Iran. The authors acknowledge personnel of the Laboratory of Microbiology for technical assistance.
Funding sources
This study was supported by the intramural fund.
Ethical statement
In this experimental study, Ethical approval of laboratory animal work was obtained from the Ethics Committee of Razi University, Kermanshah (ethical code: 397-1-03), and mice were kept in the animal room under standard condition such as 12:12 h light-dark cycle, the beginning of the lighting hour was 8 am and the beginning of darkness was set to 8 pm, at a constant temperature of 20-22°C, and free access to food and water.
Competing interests
The authors declare that there is no conflict of interest.
Authors’ contribution
KC and MA designed this experiment. MFD did this experiment, analyzed data, and drafted the manuscript. All authors revised the article. Microbiological and histological studies were performed under the supervision of KC and MA, respectively.
Research Highlights
What is the current knowledge?
simple
-
√ AgNPs play a great bactericidal role against a large number of pathogenic bacteria.
-
√ Materials and compounds based on silver have historically been used as a disinfectant.
-
√ AgNPs have potent ant-biofilm effects induced by gram-positive and negative bacteria.
-
√ Exposure to these substances has harmful effects on mammalian cells.
-
√ LC is an anti-inflammatory and antioxidant agent.
-
√ LC plays a major role in controlling inflammation by suppressing inflammatory cytokines.
-
√ LC can maintain the oxidative and metabolic state of the female reproductive system.
What is new here?
simple
-
√ Effect of AgNPs on mixed state inhibition of E. coli and S. aureus.
-
√ Effect of AgNPs on biofilm inhibition induced by both E. coli and S. aureus.
-
√ Use of AgNPs to treat AV infection in infected mice.
-
√ Use of LC to remove tissue damage caused by infection and AgNPs treatment.
-
√ Evaluation of vaginal cytology at all stages of treatment and in all test groups.
References
- Donders GG, Ruban K, Bellen G. Selecting anti-microbial treatment of aerobic vaginitis. Curr Infect Dis Rep 2015; 17:24-31. doi: 10.1007/s11908-015-0477-6 [Crossref] [ Google Scholar]
- Donders G. specialists in vulvovaginitis. Am J Obstet Gynecol 2001; 184:248-259. doi: 10.1067/mob.2001.108990 [Crossref] [ Google Scholar]
- Tansarli GS, Kostaras EK, Athanasiou S, Falagas ME. Prevalence and treatment of aerobic vaginitis among non-pregnant women: evaluation of the evidence for an underestimated clinical entity. Eur J Clin Microbiol Infect Dis 2013; 32:977-84. doi: 10.1007/s10096-013-1846-4 [Crossref] [ Google Scholar]
- Donders GG, Vereecken A, Bosmans E, Dekeersmaecker A, Salembier G. Definition of a type of abnormal vaginal flora that is distinct from bacterial vaginosis: aerobic vaginitis. Int J Obstet Gynaecol 2002; 109:34-43. doi: 10.1111/j.1471-0528.2002.00432.x [Crossref] [ Google Scholar]
- Donati L, Di Vico A, Nucci M, Quagliozzi L, Spagnuolo T, Labianca A. Vaginal microbial flora and outcome of pregnancy. Arch Gynecol Obstet 2010; 281:589-600. doi: 10.1007/s00404-009-1318-3 [Crossref] [ Google Scholar]
- Han C, Wu W, Fan A, Wang Y, Zhang H, Chu Z. Diagnostic and therapeutic advancements for aerobic vaginitis. Arch Gynecol Obstet 2015; 291:251-7. doi: 10.1007/s00404-014-3525-9 [Crossref] [ Google Scholar]
- Palmeira-de-Oliveira R, Palmeira-de-Oliveira A, Martinez-de-Oliveira J. New strategies for local treatment of vaginal infections. Adv Drug Deliv Rev 2015; 92:105-222. doi: 10.1016/j.addr.2015.06.008 [Crossref] [ Google Scholar]
- Jones SA, Bowler PG, Walker M, Parsons D. Controlling wound bioburden with a novel silver‐containing Hydrofiber® dressing. Wound Repair Regen 2004; 12:288-94. doi: 10.1111/j.1067-1927.2004.012304.x [Crossref] [ Google Scholar]
- Zhang XF, Liu ZG, Shen W, Gurunathan S. Silver nanoparticles: synthesis, characterization, properties, applications, and therapeutic approaches. Int J Mol Sci 2016; 17:1-34. doi: 10.3390/ijms17091534 [Crossref] [ Google Scholar]
- Radzig MA, Nadtochenko VA, Koksharova OA, Kiwi J, Lipasova VA, Khmel IA. Antibacterial effects of silver nanoparticles on gram-negative bacteria: influence on the growth and biofilms formation, mechanisms of action. Colloid Surfaces B Biointerfaces 2013; 102:300-306. doi: 10.1016/j.colsurfb.2012.07.039 [Crossref] [ Google Scholar]
- Salas-Orozco M, Niño-Martínez N, Martínez-Castañón GA, Méndez FT, Jasso ME, Ruiz F. Mechanisms of resistance to silver nanoparticles in endodontic bacteria: a literature review. J Nanomater 2019; 2019:1-11. doi: 10.1155/2019/7630316 [Crossref] [ Google Scholar]
- Alavi M, Karimi N, Valadbeigi T. Antibacterial, antibiofilm, antiquorum sensing, antimotility, and antioxidant activities of green fabricated Ag, Cu, TiO2, ZnO, and Fe3O4 NPs via protoparmeliopsis muralis lichen aqueous extract against multi-drug-resistant bacteria. ACS Biomater Sci Eng 2019; 5:4228-43. doi: 10.1021/acsbiomaterials.9b00274 [Crossref] [ Google Scholar]
- Stensberg MC, Wei Q, McLamore ES, Porterfield DM, Wei A, Sepúlveda MS. Toxicological studies on silver nanoparticles: challenges and opportunities in assessment, monitoring and imaging. Nanomedicine (Lond) 2011; 6:879-98. doi: 10.2217/nnm.11.78 [Crossref] [ Google Scholar]
- Kim SH, Ko JW, Koh SK, Lee IC, Son JM, Moon C. Silver nanoparticles induce apoptotic cell death in cultured cerebral cortical neurons. Mol Cell Toxicol 2014; 10:173-9. doi: 10.1007/s13273-014-0019-6 [Crossref] [ Google Scholar]
- Berni A, Meschini R, Filippi S, Palitti F, De Amicis A, Chessa L. L-carnitine enhances resistance to oxidative stress by reducing DNA damage in Ataxia telangiectasia cells. Mutat Res Genet Toxicol Environ Mutagen 2008; 650:165-74. doi: 10.1016/j.mrgentox.2007.11.008 [Crossref] [ Google Scholar]
- Kart AS, Yapar KÜ, Karapehlivan MA, Tunca RE, Ogun ME, Citil ME. Effects of L-carnitine on kidney histopathology, plasma and tissue total sialic acid, malondialdehyde and glutathione concentrations in response to gentamicin administration in Balb/C mice. Rev Med Vet 2006; 157:179-181. [ Google Scholar]
- Liu F, Mahmood M, Xu Y, Watanabe F, Biris AS, Hansen DK. Effects of silver nanoparticles on human and rat embryonic neural stem cells. Front Neurosci 2015; 9:115-124. doi: 10.3389/fnins.2015.00115 [Crossref] [ Google Scholar]
- Duranay M, Akay H, Yilmaz FM, Şeneş M, Tekeli N, Yücel D. Effects of L-carnitine infusions on inflammatory and nutritional markers in haemodialysis patients. Nephrol Dial Transplant 2006; 21:3211-3214. doi: 10.1093/ndt/gfl356 [Crossref] [ Google Scholar]
- Akoachere JT, Bughe RN, Oben BO, Ndip LM, Ndip RN. Phenotypic characterization of human pathogenic bacteria in fish from the coastal waters of South West Cameroon: Public health implications. Rev Environ Health 2009; 24:147-56. doi: 10.1515/REVEH.2009.24.2.147 [Crossref] [ Google Scholar]
- Ahluwalia V, Kumar J, Sisodia R, Shakil NA, Walia S. Green synthesis of silver nanoparticles by Trichoderma harzianum and their bio-efficacy evaluation against Staphylococcus aureus and Klebsiella pneumonia. Ind Crops Prod 2014; 55:202-206. doi: 10.1016/j.indcrop.2014.01.026 [Crossref] [ Google Scholar]
- Ahluwalia V, Elumalai S, Kumar V, Kumar S, Sangwan RS. Nano silver particle synthesis using Swertia paniculata herbal extract and its antimicrobial activity. Microb Pathogen 2018; 114:402-8. doi: 10.1016/j.micpath.2017.11.052 [Crossref] [ Google Scholar]
- Namasivayam SK, Christo BB, Arasu SK, Kumar KA, Deepak K. Anti biofilm effect of biogenic silver nanoparticles coated medical devices against biofilm of clinical isolate of Staphylococcus aureus. Glob J Med Res 2013:1-7.
- Tendolkar PM, Baghdayan AS, Gilmore MS, Shankar N. Enterococcal surface protein, Esp, enhances biofilm formation by Enterococcus faecalis. Infect Immun 2004; 72:6032-9. doi: 10.1128/IAI.72.10.6032-6039.2004 [Crossref] [ Google Scholar]
- Colvin VL. Colvin VLThe potential environmental impact of engineered nanomaterialsnanomaterials. Nat Biotechnol 2003; 21:1166-1170. doi: 10.1038/nbt875 [Crossref] [ Google Scholar]
- Kalhori Z, Mehranjani MS, Azadbakht M, Shariatzadeh MA. l-Carnitine improves endocrine function and folliculogenesis by reducing inflammation, oxidative stress and apoptosis in mice following induction of polycystic ovary syndrome. Reprod Fertil Dev 2019; 31:282-293. doi: 10.1071/RD18131 [Crossref] [ Google Scholar]
- Xiu W, Jianchun L, Yuzhen H, Wenyang C, Yiguang J. Effect of Sophora flavescens alkaloid on aerobic vaginitis in gel form for local treatment. J Trad Chin Med 2017; 37:314-320. doi: 10.1016/S0254-6272(17)30066-3 [Crossref] [ Google Scholar]
- Zárate G, Santos V, Nader-Macias ME. Protective effect of vaginal Lactobacillus paracasei CRL 1289 against urogenital infection produced by Staphylococcus aureus in a mouse animal model. Infect Dis Obstet Gynecol 2007; 2007:48358. doi: 10.1155/2007/48358 [Crossref] [ Google Scholar]
- Surai PF. Antioxidant action of carnitine: molecular mechanisms and practical applications. EC Vet Sci 2015; 2:66-84. [ Google Scholar]
- Zarbo G, Coco L, Leanza V, Genovese F, Leanza G, D’Agati A. Aerobic vaginitis during pregnancy. Res Obstet Gynecol 2013; 2:7-11. doi: 10.5923/j.rog.20130202.01 [Crossref] [ Google Scholar]
- Cleveland AM. Vaginitis: Finding the cause prevents treatment failure. Cleve Clin J Med 2000; 67:634-46. doi: 10.3949/ccjm.67.9.634 [Crossref] [ Google Scholar]
- Li WR, Xie XB, Shi QS, Zeng HY, You-Sheng OY, Chen YB. Antibacterial activity and mechanism of silver nanoparticles on Escherichia coli. Appl Microbiol Biotechnol 2015; 85:1115-22. doi: 10.1007/s00253-009-2159-5 [Crossref] [ Google Scholar]
- Xu H, Qu F, Xu H, Lai W, Wang YA, Aguilar ZP. Role of reactive oxygen species in the antibacterial mechanism of silver nanoparticles on Escherichia coli O157: H7. Biometals 2012; 25:45-53. doi: 10.1007/s10534-011-9482-x [Crossref] [ Google Scholar]
- Alavi M, Karimi N. Characterization, antibacterial, total antioxidant, scavenging, reducing power and ion chelating activities of green synthesized silver, copper and titanium dioxide nanoparticles using Artemisia haussknechtii leaf extract. Artif Cells Nanomed Biotechnol 2018; 46:2066-81. doi: 10.1080/21691401.2017.1408121 [Crossref] [ Google Scholar]
- Kim SH, Lee HS, Ryu DS, Choi SJ, Lee DS. Antibacterial activity of silver-nanoparticles against Staphylococcus aureus and Escherichia coli. Korean J Microbiol Biotechnol 2011; 39:77-85. [ Google Scholar]
- Hulla JE, Sahu SC, Hayes AW. Nanotechnology: History and future. Hum Expe Toxicol 2015; 34:1318-1321. doi: 10.1177/0960327115603588 [Crossref] [ Google Scholar]
- Hendrickson OD, Klochkov SG, Novikova OV, Bravova IM, Shevtsova EF, Safenkova IV. Toxicity of nanosilver in intragastric studies: biodistribution and metabolic effects. Toxicol Lett 2016; 241:184-192. doi: 10.1016/j.toxlet.2015.11.018 [Crossref] [ Google Scholar]
- Chen D, Yang Z. Tissue toxicity following the vaginal administration of nanosilver particles in rabbits. Regen Biomater 2015; 2:261-265. doi: 10.1093/rb/rbv016 [Crossref] [ Google Scholar]
- Sengupta P, Banerjee R, Nath S, Das S, Banerjee S. Metals and female reproductive toxicity. Hum Exp Toxicol 2015; 34:679-697. doi: 10.1177/0960327114559611 [Crossref] [ Google Scholar]
- Ferraresi R, Troiano L, Roat E, Nemes E, Lugli E, Nasi M, Iannuccelli M, Cossarizza A. Protective effect of acetyl‐l‐carnitine against oxidative stress induced by antiretroviral drugs. FEBS Lett 2006; 580:6612-6616. doi: 10.1016/j.febslet.2006.11.016 [Crossref] [ Google Scholar]
- Agarwal A, Sengupta P, Durairajanayagam D. Role of L-carnitine in female infertility. Reprod Biol Endocrinol 2018; 16:1-5. doi: 10.1186/s12958-018-0323-4 [Crossref] [ Google Scholar]